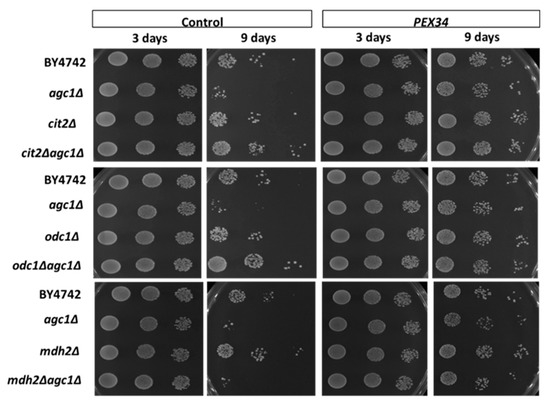

Abstract
Citrin is a liver-specific mitochondrial aspartate–glutamate carrier encoded by SLC25A13. Citrin deficiency caused by SLC25A13 mutation results in carbohydrate toxicity, citrullinemia type II, and fatty liver diseases, the mechanisms of some of which remain unknown. Citrin shows a functional homolog in yeast aspartate-glutamate carrier (Agc1p) and agc1Δ yeasts are used as a model organism of citrin deficiency. Here, we found that agc1Δ yeasts decreased fat utilization, impaired NADH balance in peroxisomes, and decreased chronological lifespan. The activation of GPD1-mediated NAD+ regeneration in peroxisomes by GPD1 over-expression or activation of the malate–oxaloacetate NADH peroxisomal shuttle, by increasing flux in this NADH shuttle and over-expression of MDH3, resulted in lifespan extension of agc1Δ yeasts. In addition, over-expression of PEX34 restored longevity of agc1Δ yeasts as well as wild-type cells. The effect of PEX34-mediated longevity required the presence of the GPD1-mediated NADH peroxisomal shuttle, which was independent of the presence of the peroxisomal malate–oxaloacetate NADH shuttle and PEX34-induced peroxisome proliferation. These data confirm that impaired NAD+ regeneration in peroxisomes is a key defect in the yeast model of citrin deficiency, and enhancing peroxisome function or inducing NAD+ regeneration in peroxisomes is suggested for further study in patients’ hepatocytes.
1. Introduction
Citrin deficiency is an inherited non-alcoholic fatty liver disease commonly found in the Asia–Pacific population [1,2,3]. This disorder results from a loss-of-function mutation in SLC25A13 encoding a mitochondrial aspartate–glutamate carrier, called citrin or AGC2, that appears to have a primary role in the liver [4,5]. Citrin deficiency results in an impaired malate–aspartate shuttle and decreased NAD+ regeneration in the cytosol leading to carbohydrate intolerance and type II citrullinemia (CTLN2) [6,7]. Current therapies for citrin deficiency are limited, although treatment with sodium pyruvate, arginine hydrochloride, and restriction of carbohydrate intake has shown promise in reducing symptoms [7,8].
Saccharomyces cerevisiae (budding yeast) has been shown to be a suitable model system for the study of several human diseases, including citrin deficiency [9,10]. S. cerevisiae is a genetically tractable organism and can be used to search for genetic suppressors to identify functional relationships between genes that may not otherwise be identified via other techniques [11]. Yeast contains a homolog of citrin, AGC1, and the deletion of this gene results in decreased growth in acetate and oleic media [12]. Ectopic expression of SLC25A13 in agc1Δ yeasts can restore growth in acetate medium, demonstrating that yeast AGC1 is functionally equivalent to human citrin [10,12].
In addition to mitochondria, peroxisomes can contribute to utilization of acetate and fatty acids [13,14,15]. Loss of AGC1 in yeasts impairs growth in acetate and oleic media, but not in glycerol medium, suggesting that it likely affects peroxisomal rather than mitochondrial functions [10]. Peroxisomes are single-membrane-bound organelles derived from the endoplasmic reticulum (ER) and are found in eukaryotic cells including those of both yeasts and humans [16]. A major function of peroxisomes is to support mitochondrial metabolism through fatty acid oxidation as well as degradation of hydrogen peroxide, and these activities are induced in yeast following entry into the stationary phase of growth [16,17,18]. Survival of yeast in the stationary phase has been extensively utilized as a model of aging and is referred to as the chronological lifespan [19]. In this study, we report that agc1Δ yeast have impaired peroxisomal NAD+ regeneration, decreased fat utilization, and decreased chronological lifespan. Genetic analysis of agc1Δ yeast has revealed that the induction of peroxisome functions relating to NAD+ regeneration is capable of increasing the longevity of agc1Δ yeast. The reduced lifespan of human hepatocytes with a loss-of-function mutation in citrin may contribute to disease progression. Therefore, enhancing peroxisome function may be an alternative treatment for citrin deficiency.
2. Materials and Methods
2.1. Primers and Plasmids
The AGC1 disruption plasmid was generated by PCR amplifying upstream (−931 to −114) and downstream sequences (+2499 to +3478) of ACG1 introducing BamHI and SalI (upstream) or NotI and BamHI (downstream) restriction sites. Following digestion, the AGC1 DNA fragments were inserted into pRS403 (HIS3) [20]. The expression plasmids including PEX34, PEX5, PEX11, MDH3, GPD1, and NDE2 expression plasmids were constructed using Ycplac33 (CEN URA3) vector, a yeast centromeric plasmid containing the URA3 selectable marker and the TPI1 promoter [21]. The NADH sensor plasmids were derived from pC1-REX-YFP, a gift from Vsevolod Belousov (Addgene plasmid #48247). The REX-YFP fusion protein will interact with NADH and can emit fluorescent signals [22]. pC1-REX-YFP was introduced at 5′ XbaI and NdeI sites by PCR mutagenesis and verified. The mutated pC1-REX-YFP was digested with XbaI and SacII to obtain the NADH sensor sequence. The backbone plasmid pLJ339 (PGK1 promoter, CEN, LEU2), a yeast centromeric plasmid containing the LEU2 selectable marker and the PGK1 promoter, was digested with the same enzymes. The NADH sensor sequence was then ligated to the isolated pLJ339 backbone plasmid. The cytosolic NADH sensor plasmid was selected and verified. To construct the peroxisomal NADH sensor plasmid, the NADH sensor sequence in the cytosolic NADH sensor plasmid was introduced a C-terminal peroxisomal targeting sequence by PCR mutagenesis. The cytosolic NADH sensor plasmid was selected and verified. The lists of primers used in the study is shown in Supplementary Table S1.
2.2. Yeast Strains and Disruption of AGC1
Yeast strains used in this study were derived from BY4742 [23]. Single-deletion yeast strains were obtained from Open Biosystems, Inc. (Waltham, MA, USA). The AGC1 gene was disrupted using the knockout plasmid, linearized by digestion with BamH1, and transformed into yeast strains. The AGC1 gene of yeast was replaced with the HIS3 selectable marker by homologous recombination. Correct plasmid integration and deletion of AGC1 sequences was verified by in vivo PCR using flanking primers [24]. The lists of yeast strains and genotypes used in the study is shown in Supplementary Table S2.
2.3. Yeast Transformation
The control plasmid (pRS316), expression plasmids, and linearized AGC1 disruption plasmids were transformed into specific yeast strains using a lithium acetate procedure [25]. Cells were propagated at 30 °C either in enriched yeast extract, peptone-based medium (YPD), synthetic complete (SC), or synthetic deficient (SD) medium containing 2% glucose [26]. Yeast transformants were selected on SC medium lacking the appropriate nutrient.
2.4. Culture Conditions and Longevity Assay
Yeasts were grown on synthetic deficient (SD) plate supplemented with 2% glucose incubated in a 30 °C incubator for three days. Then, they were pre-cultured in synthetic SD broth containing 2% glucose by incubation at 30 °C, with shaking at 220 rpm for 24 h. Cells were harvested and inoculated in SD broth with 2% glucose at a starting optical density 600 nm (OD600) of 0.1 and grown for nine days. The chronological longevity assay was used to determine survival in the stationary phase [19]. Cell survival was monitored at Day 3 and Day 9 of culture. Yeast cells were collected and washed twice with sterile distilled water. The OD600 was measured, and samples were prepared in sterile distilled water at 105, 104, and 103 cells. Yeasts (10 µL each) were dropped on an SD plate supplemented with 2% glucose, incubated at 30 °C for 72 h, and then imaged.
2.5. Peroxisomal and Cytosolic NADH Analysis, Peroxisome Proliferation Analysis, and Confocal Fluorescence Microscopy
To analyze peroxisomal and cytosolic NADH fluorescence signals, yeasts were grown on an SD plate supplemented with 2% glucose incubated in a 30 °C incubator for five days and then directly taken for visualizing NADH signals with confocal fluorescence microscopy. The excitation and emission wavelengths were chosen at 488/510 nm. The small punctate green fluorescence represented peroxisomal NADH signals and the diffuse green fluorescence represented cytosolic NADH signals. To analyze peroxisome proliferation, yeasts were grown on an SD plate supplemented with 2% glucose for three days. Then, they were cultured in SD broth supplemented with 0.1% glucose until late log phase. The punctate signals from red fluorescent protein (RFP) fusions RFP-PTS1 (peroxisome marker) represented peroxisome numbers [27]. To visualize fluorescence signals derived from NADH sensor protein or RFP-PTS1 protein, the live cells were directly viewed at a magnification of 60× with an Olympus FV1000 confocal laser scanning microscope (Olympus Bioimaging Center, Mahidol University).
2.6. Neutral Lipid Staining and Spectrofluorometry
To analyze neutral lipids (esterified fatty acids), yeasts were precultured and cultured the same as for longevity assays. Cells were taken for staining neutral lipids with Nile red fluorescence dye at Day 3 and Day 9 of culture. One milliliter of cell volumes was collected, washed with phosphate buffered saline twice, and resuspended to OD600nm 1.0 (2 × 104 cell/µL). Then, 250 µL of cell volumes (5 × 106 cells) was incubated with dimethyl sulfoxide: phosphate buffered saline 1:1 for 2 min in one well of a 96-well plate. Yeasts were then stained with 25 µL of Nile red (60 µg/mL). The fluorescence signals in 5 µg/mL of Nile red were read for 20 min (read every 1 min × 20 cycles) during shaking at 180 rpm at 30 °C in a spectrofluorometer machine. The excitation and emission wavelength were chosen at 485/535 nm. The experiment was performed in triplicate, and the highest fluorescence intensity prior to plateau was chosen for analysis. The relative fluorescence intensity was corrected with background fluorescence intensity obtained from the control well. Neutral lipid contents in yeasts were presented as relative fluorescence units.
2.7. Data Analysis
The difference in neutral lipid contents was analyzed by IBM SPSS statistics version 22. Statistical analyses within groups were done using paired-samples t tests (paired t-test) and a significant difference was indicated when p-value <0.05. Yeasts with neutral lipid staining were derived in triplicate from one repeated experiment.
3. Results
3.1. Deletion of AGC1 Inhibits Fat Utilization in the Stationary Phase
Fatty acid is esterified and stored in fat droplets in cytosol as an energy reserve in yeast cells. It will be liberated from triacylglycerol and oxidized in peroxisomes when cells enter the stationary phase. Fatty acid oxidation requires plenty of NAD+ as a coenzyme which is continually supplied by Mdh3p and Gpd1p activity in peroxisomes (Figure 1a). Mdh3p is malate dehydrogenase localizing in peroxisomes and Gpd1p is glycerol 3-phosphate dehydrogenase localizing in both cytosolic and peroxisomal compartments [28]. The substrate for Mdh3p is oxaloacetate derived from aspartate transamination which is replenished by Agc1p activity (Figure 1a). As seen in Figure 1b, deletion of AGC1 decreased fat utilization in the stationary phase, but deletion of GPD1 decreased both of fat storage and fat utilization. Interestingly, deletion of AGC1 in gpd1Δ yeasts restored the capability of fat storage and fat utilization in the stationary phase.

Figure 1.
Role of mitochondrial aspartate–glutamate carrier (Agc1p) in the malate–aspartate shuttle involved in fatty acid oxidation in peroxisomes and alteration of fat utilization of agc1Δ yeasts and related yeast mutants in the stationary phase. (a) The malate–aspartate shuttle in yeasts is required for NAD+ regeneration in peroxisomes with the transfer of the reducing equivalent from peroxisome into mitochondria. Reducing equivalents generated in peroxisomes are derived from fatty acid oxidation which is enhanced by Mdh3p-mediated and Gpd1p-mediated NAD+ regeneration in peroxisomes. Note that both the malate–oxaloacetate NADH shuttle (dot line) and the malate–aspartate shuttle are linked for NAD+ regeneration in peroxisomes. (b) Wild-type and yeast mutants including agc1Δ, gpd1Δ, and gpd1Δagc1Δ cells in stationary phase were selected for neutral lipid staining with Nile red fluorescence dye and then the fluorescence intensity was measured with spectrofluorometry. Note that deletion of AGC1 decreased fat utilization, but deletion of GPD1 decreased both of fat storage and utilization in the stationary phase. Deletion of AGC1 in gpd1Δ yeasts restored fat storage and fat utilization in the stationary phase. Abbreviations: Asp, aspartate; Glu, glutamate; OAA, oxaloacetate; α-KG, α-ketoglutarate, Agc1p, aspartate–glutamate carrier, Odc1p, oxodicarboxylate carrier; Mdh3p, malate dehydrogenase3; Gpd1p, glycerol 3-phosphate dehydrogenase; DHAP, dihydroxyacetone phosphate; G3-P, glycerol 3-phosphate dehydrogenase. ** p ≤ 0.01.
3.2. Deletion of AGC1 Increases Peroxisomal NADH Signals, but Decreases Cytosolic NADH Signals in the Stationary Phase
NAD+ regeneration in peroxisomes supplies NAD+ for fatty acid oxidation. To further explain whether impaired fat utilization in agc1Δ yeasts is due to decreased NAD+ regeneration in peroxisomes, we demonstrated peroxisomal NADH signals in yeasts by peroxisomal NADH sensor plasmids. As shown in Figure 2, increased peroxisomal NADH signals, which are represented as small punctate green fluorescence signals, were observed in agc1Δ, gpd1Δ, and gpd1Δagc1Δ yeasts. Deletion of GPD1 showed slightly higher peroxisomal NADH signal intensity relative to others. However, some NADH signals induced by peroxisome NADH sensor plasmids were also found in the cytoplasm. In addition, we used cytosolic NADH sensor plasmids to directly demonstrate cytosolic NADH signals which might be affected in agc1Δ and gpd1Δ yeasts. The results showed that the cytosolic NADH signals were decreased in agc1Δ and gpd1Δ yeasts, but these signals were restored in gpd1Δagc1Δ yeasts. As seen in Figure 2, some NADH signals induced by cytosolic NADH sensor plasmids were also observed in peroxisomes.

Figure 2.
Deletion of AGC1 increases peroxisomal NADH signals but decreases cytosolic NADH signals in the stationary phase. Yeasts containing peroxisomal and cytosolic NADH sensor plasmids were grown in a synthetic deficient (SD) medium plate supplemented with 2% glucose for five days and then taken for visualizing NADH signals with confocal fluorescence microscopy. The small punctate green fluorescence signals represented NADH localizing in peroxisomes. Note that deletion of GPD1 showed similar effects as deletion of AGC1, and deletion of AGC1 in gpd1Δ cells also restored cytosolic NADH signals. In addition, cytosolic NADH signals induced by peroxisomal NADH sensor plasmids and peroxisomal NADH signals induced by cytosolic NADH sensor plasmids were observed.
3.3. Over-Expression of PEX34, MDH3, GPD1 Increases the Longevity of agc1Δ Yeasts in the Stationary Phase
Peroxisome functions are important for the stationary phase of cell growth, and deletion of ACG1 impairs utilization of acetate and oleic acid, which are important carbon sources in the stationary phase [12,17,19]. Peroxisome biogenesis requires both proliferation of the peroxisome structure and import of peroxisomal proteins. PEX34 and PEX11 function in peroxisome proliferation [16]. In contrast, PEX5 functions in the import of peroxisome matrix proteins, such as Mdh3p, which is important for NAD+ regeneration in peroxisomes [16,28].
As seen in Figure 3, deletion of AGC1 decreased the chronological lifespan of yeast cells. Over-expression of Pex34p, Pex5p, and Mdh3p in agc1Δ cells increased lifespan, but the over-expression of Pex34p, and Pex11p increased longevity in wild-type cells. Interestingly, over-expression of Gpd1 in agc1Δ cells also increased the chronological lifespan and over-expression of Nde2p, which is an external NADH dehydrogenase in the mitochondria required for catalyzing NADH in cytosol [29], failed to restore the chronological lifespan of agc1Δ cells. Conversely, over-expression of Nde2p and Gpd1p increased the chronological lifespan of wild-type yeasts.

Figure 3.
Effects of over-expression of peroxisomal genes and NAD+ regeneration genes on the chronological longevity of agc1Δ yeasts. Wild-type and agc1Δ yeasts containing expression plasmids of peroxisomal genes and NAD+ regeneration genes as indicated were cultured in SD broth supplemented with 2% glucose and tested for chronological longevity. The yeast array on an SD plate supplemented with 2% glucose indicated viability starting with 105, 104, and 103 cells. Note that agc1Δ yeasts had decreased chronological longevity, and GPD1, MDH3, and PEX34 over-expression increased the longevity of agc1Δ yeasts.
3.4. PEX34-Mediated Chronological Longevity Requires GPD1 but not PEX25 and PEX27
We have known that the induction of NAD+ regeneration in peroxisomes was a primary mechanism of chronological longevity in agc1Δ yeasts. To determine whether MDH3 was important for increased longevity from over-expression of PEX34, we examined the lifespan of an agc1Δmdh3Δ strain. The increased chronological lifespan in agc1Δ cells from PEX34 over-expression was still apparent, although reduced, when MDH3 was also deleted (Figure 4). This indicates that while over-expression of MDH3 can extend yeast lifespan, this gene does not have a major role in lifespan extension from PEX34 over-expression. In addition, we determined whether GPD1 was important for promoting longevity in agc1Δ yeasts. Interestingly, PEX34 over-expression in the gpd1Δ strain caused decreased longevity; however, the negative effect of PEX34 was abolished in the agc1Δgpd1Δ strain (Figure 4). Unlike the parental agc1Δ strain, PEX34 over-expression was unable to substantially increase longevity when GPD1 was deleted. This observation is consistent with GPD1 participating in the PEX34-mediated extension of lifespan in agc1Δ cells.

Figure 4.
PEX34-mediated longevity requires peroxisomal genes for NAD+ regeneration, but not for peroxisome proliferation. Yeasts lacking genes involved in NAD+ regeneration in the peroxisome (MDH3, GPD1) and peroxisome proliferation (PEX25, PEX27) were tested for chronological longevity under PEX34 over-expression. The yeast array on an SD plate supplemented with 2% glucose indicated viability starting with 105, 104, and 103 cells. Note that PEX34-mediated longevity requires GPD1 expression and loss of GPD1 decreased the longevity at the early stationary phase.
We also investigated whether the induction of peroxisome proliferation was involved in PEX34-mediated longevity in agc1Δ yeast. PEX25 and PEX27 encode peroxisome membrane proteins that physically interact with Pex34p and are required for PEX34-induced peroxisome proliferation [30]. We observed that the PEX34-mediated longevity of wild-type and agc1Δ yeasts was not reduced in the absence of either PEX25 or PEX27 (Figure 4). In addition, we investigated peroxisome numbers under PEX34 over-expression in limited glucose conditions and found that PEX34 induced peroxisome proliferation in both wild-type and agc1Δ yeasts. It was noticed that PEX34 over-expression also induced the proliferation of tiny peroxisomes (Figure 5). Moreover, PEX34 partially restored the number of peroxisomes in pex25Δ yeasts but failed to restore the number of peroxisomes in pex27Δ yeasts (Figure 5). These data confirm that the induction of peroxisome proliferation is not a primary mechanism for PEX34-mediated longevity.

Figure 5.
PEX34-induced peroxisome proliferation requires PEX27 under a limited glucose condition. Yeasts lacking genes involved in peroxisome proliferation (PEX25, PEX27) containing peroxisome marker plasmid (RFP-PTS1) were tested for visualizing peroxisomes under PEX34 over-expression. Yeasts were grown in SD broth supplemented with 0.1% glucose until late log phase and then used for imaging peroxisomes with confocal fluorescence microscopy. The red-dot signal represented peroxisomes. Note that PEX34 over-expression induced the proliferation of tiny peroxisomes.
3.5. Role of Malate–Oxaloacetate NADH Perosixomal shuttle in Chronological Longevity of agc1Δ Yeast
We investigated whether disruption of the malate–oxaloacetate NADH shuttle was sufficient to induce longevity of agc1Δ cells. CIT2 encodes a peroxisomal citrate synthase that catalyzes the conversion of oxaloacetate and acetyl CoA to citrate and coenzyme A. ODC1 encodes a mitochondrial oxodicarboxylate carrier, mediating exchange transport of malate and α-ketoglutarate between the cytosol and mitochondria [31,32]. It has been reported that CIT2 and ODC1 activity disrupt the malate–oxaloacetate NADH peroxisomal shuttle [32,33]. As seen in Figure 6, deletion of either CIT2 or ODC1 increased the lifespan of agc1Δ yeast.
Figure 6.
Activation of the malate–oxaloacetate NADH peroxisomal shuttle is sufficient for inducing longevity of agc1Δ yeasts, but the malate–oxaloacetate NADH peroxisomal shuttle is NOT essential for PEX34-mediated longevity in yeasts. Yeasts lacking genes disrupting the peroxisomal malate–oxaloacetate NADH shuttle (CIT2, ODC1) and genes required for this shuttle (MDH2) were tested for cell viability during the stationary phase under PEX34 over-expression. The yeast array on an SD plate supplemented with 2% glucose indicated viability starting with 105, 104, and 103 cells.
Mdh3p and Mdh2p enzymes are components of the peroxisomal malate–oxaloacetate NADH shuttle [28]. We have examined that PEX34-mediated chronological longevity required GPD1 for NAD+ regeneration in peroxisomes. However, deletion of MDH3 slightly decreased the PEX34-mediated chronological longevity of agc1Δ yeasts (Figure 4). Interestingly, PEX34 over-expression was capable of increasing longevity in the agc1Δmdh2Δ strain (Figure 6). This indicates that MDH2 is not required for PEX34-mediated longevity in agc1Δ cells and is consistent with increased longevity from PEX34 over-expression from GPD1-mediated NAD+ regeneration in peroxisomes without flux through the malate–oxaloacetate NADH shuttle (Figure 7).

Figure 7.
Summary of genetic mechanisms to restore the chronological longevity of agc1Δ yeasts. There are five genetic mechanisms for restoring the longevity of agc1Δ yeasts, including activation of PEX34 over-expression (1), GPD1 over-expression (2), deletion of CIT2 (3), MDH3 over-expression (4), and deletion of ODC1 (5). The principle of the genetic mechanism for restoring longevity of agc1Δ yeasts is that induction of GPD1-mediated NAD regeneration in peroxisomes (1,2) and enhanced peroxisomal malate–oxaloacetate NADH shuttle activity (3–5). Abbreviations: Asp, aspartate; Glu, glutamate; OAA, oxaloacetate; α-KG, α-ketoglutarate, Agc1p, aspartate–glutamate carrier, Odc1p, oxodicarboxylate carrier; Mdh3p, malate dehydrogenase3; Mdh2p, malate dehydrogenase2; Cit2p, citrate synthase2; Gpd1p, glycerol 3-phosphate dehydrogenase 1; DHAP, dihydroxyacetone phosphate; G3-P, glycerol 3-phosphate.
4. Discussion
The models previously used to study the pathogenesis of citrin deficiency were citrin/mitochondrial glycerol 3-phosphate dehydrogenase (mGPD) double-knockout mice and patients’ hepatocytes [1,34]. In this study, we firstly proposed agc1Δ yeasts to be used as a model organism to study the pathogenesis of citrin deficiency and investigated the effects of peroxisomal genes on the longevity of agc1Δ yeasts. The advantage of yeast in this study is its short lifespan through which we can observe chronological longevity. Moreover, yeasts contain haploid chromosomes which can easily be genetically manipulated to suit our experimental design. Although, yeasts are evolutionarily diverse from human hepatocytes and some peroxisomal genes are specific in yeast species, the basic functions in yeasts, such as fatty acid oxidation, NAD+ regeneration, and peroxisome proliferation, also exist in human hepatocytes. Therefore, the information from this study can provide some points to further study in citrin deficiency patients.
In our study, deletion of AGC1, encoding the mitochondrial aspartate–glutamate carrier, results in decreased fat utilization, decreased cytosolic NADH, and increased peroxisomal NADH signals in the stationary phase. These data suggest that loss of AGC1 causes impaired NAD+ regeneration in peroxisomes resulting in decreased fatty acid oxidation with reduced production of reducing equivalents in the cytosol. These results are similar to the deletion of GPD1, encoding glycerol 3-phosphate dehydrogenase required for NAD+ regeneration in peroxisomes. Moreover, the deletion of GPD1 also impaired fat storage at the early stationary phase. As known, Gpd1p is also required for production of glycerol, which plays role in triacylglycerol synthesis, so loss of Gpd1p results in decreased fat storage. Interestingly, deletion of AGC1 in gpd1Δ cells could restore fat storage, fat utilization, and correct NADH balance in the cytosol by unknown mechanisms, which are being further investigated. Moreover, the deletion of AGC1 results in decreased lifespan in yeasts and over-expression of GPD1 or MDH3, which directly enhances NAD regeneration in peroxisomes and could restore the longevity of agc1Δ cells. Moreover, enhanced activity of the malate–oxaloacetate NADH peroxisomal shuttle, due to deletion of CIT2 and ODC1, could restore or even enhance the longevity of agc1Δ cells. Collectively, it confirmed that the impaired NAD+ regeneration in peroxisomes is a cause of decreased chronological lifespan of agc1Δ cells.
PEX34 over-expression can induce chronological longevity of agc1Δ as well as wild-type yeasts. PEX34 is required for peroxisome proliferation, and over-expression of PEX34 induces peroxisome proliferation in oleic medium, through a process that is dependent on Pex25p and Pex27p [30]. However, PEX34-mediated increased longevity was independent of the presence of PEX25 and PEX27, but PEX34-mediated peroxisome proliferation required the presence of PEX27 under a limited glucose condition. This suggests that peroxisomal proliferation is not the primary mechanism involved in promoting increased lifespan from PEX34 over-expression. Consistent with this proposal, over-expression of PEX11, which can induce peroxisome proliferation in oleic medium [13], did not increase the longevity of agc1Δ cells. Interestingly, we demonstrated that PEX34-mediated longevity needs GPD1 expression. The ability of PEX34 to promote longevity in agc1Δ cells was observed in the absence of MDH2 and MDH3, required for the peroxisomal malate–oxaloacetate NADH shuttle. This suggests that another mechanism is involved in GPD1-dependent lifespan extension from PEX34 over-expression. Moreover, over-expression of GPD1 itself increases the chronological lifespan of both wild-type and agc1Δ cells, but over-expression of MDH3 increases the chronological lifespan in agc1Δ cells only, indicating that the GPD1-induced longevity mechanisms are not specific and may induce other mechanisms with NAD+ regeneration in peroxisomes. Gpd1p is required for glycerol production, which can protect cells under several stress conditions, such as osmotic stress, oxidative stress, or ER stress [35,36]. Our group has previously shown that PEX34 over-expression results in aberrant ER morphology and induces ER stress in an acetate medium [37]. It is possible that PEX34 over-expression also induces ER stress in the stationary phase of glucose-grown cells, resulting in the induction of GPD1-mediated NAD+ regeneration in peroxisomes. Enhanced chronological lifespan can also be mediated by the activation of mitochondrial retrograde and oxidative stress responses to overcome mitochondrial stresses [38,39]. We have previously shown that PEX34 over-expression induced mitochondrial retrograde signaling in acetate medium [37], suggesting that PEX34 over-expression can induce these stress responses resulting in increased longevity in yeasts.
Citrin deficiency results in intrahepatic cholestasis and fatty liver. The mechanisms of intrahepatic cholestasis and fatty liver in citrin deficiency might be involved in impaired bile acid conjugation and impaired fatty acid oxidation, which requires NAD+ regeneration in peroxisomes [1,7,40,41]. Administration of sodium pyruvate has the potential to increase NAD+ regeneration in peroxisomes, due to the presence of lactate dehydrogenases in both peroxisome and cytosolic compartments in human cells [42]. Moreover, current evidence revealed malate dehydrogenase in hepatic peroxisomes [42], indicating the presence of a peroxisomal malate–oxaloacetate NADH shuttle in humans. Based on our findings, activation the hepatic malate–oxaloacetate NADH shuttle may reduce the symptoms of citrin deficiency. Moreover, activation of peroxisome proliferator-activated receptor-alpha (PPARα) induces fatty acid oxidation in both the peroxisome and mitochondria [43]. Administration of the PPARα drug in humans might increase NAD+ regeneration in peroxisomes and decrease fatty liver in citrin-deficient patients, as well as restore cellular lifespan to levels seen in normal cells.
5. Conclusions
Peroxisomal dysfunctions observed using the yeast model for citrin deficiency appear to result in decreased cellular longevity. Processes that enhance peroxisomal NAD+ regeneration, either directly or indirectly, can increase chronological lifespan in agc1Δ yeast (Figure 7). Enhancing peroxisome function or inducing NAD+ regeneration in peroxisomes are suggested for further study in patients’ hepatocytes.
Supplementary Materials
The following are available online at https://www.mdpi.com/2079-9721/8/1/2/s1, Table S1: Primer names and their sequences used in this study, Table S2: Yeast genotypes used in this study.
Author Contributions
Conceptualization, C.C. and L.T.J.; methodology, C.C.; validation, C.C. and T.T.; formal analysis, C.C.; investigation, C.C. and T.T.; resources, L.T.J.; data curation, C.C.; writing—original draft preparation, C.C.; writing—review and editing, C.C., D.W., and L.T.J.; visualization, C.C.; supervision, D.W. and L.T.J.; project administration, C.C.; funding acquisition, C.C., D.W., and L.T.J. All authors have read and agreed to the published version of the manuscript.
Funding
This research was funded by a grant from the Mahidol University (to D.W.), a joint grant from the Faculty of Science and Faculty of Medicine, Ramathibodi Hospital, Mahidol University (to L.J. and D.W.), a grant from the Faculty of Medicine, Khon Kaen University (to C.C.), and a grant from the Thailand Research Fund IRG5980008. The article processing charge (APC) was paid by C.C.
Acknowledgments
The authors gratefully acknowledge all L.J.’s lab members for technical support.
Conflicts of Interest
The authors declare no conflict of interest.
References
- Komatsu, M.; Kimura, T.; Yazaki, M.; Tanaka, N.; Yang, Y.; Nakajima, T.; Horiuchi, A.; Fang, Z.Z.; Joshita, S.; Matsumoto, A.; et al. Steatogenesis in adult-onset type II citrullinemia is associated with down-regulation of PPARalpha. Biochim. Biophys. Acta 2015, 1852, 473–481. [Google Scholar] [CrossRef]
- Shigematsu, Y.; Hirano, S.; Hata, I.; Tanaka, Y.; Sudo, M.; Sakura, N.; Tajima, T.; Yamaguchi, S. Newborn mass screening and selective screening using electrospray tandem mass spectrometry in Japan. J. Chromatogr. B 2002, 776, 39–48. [Google Scholar] [CrossRef]
- Wongkittichote, P.; Sukasem, C.; Kikuchi, A.; Aekplakorn, W.; Jensen, L.T.; Kure, S.; Wattanasirichaigoon, D. Screening of SLC25A13 mutation in the Thai population. World J. Gastroenterol. 2013, 19, 7735–7742. [Google Scholar] [CrossRef]
- Kobayashi, K.; Sinasac, D.S.; Iijima, M.; Boright, A.P.; Begum, L.; Lee, J.R.; Yasuda, T.; Ikeda, S.; Hirano, R.; Terazono, H.; et al. The gene mutated in adult-onset type II citrullinaemia encodes a putative mitochondrial carrier protein. Nat. Genet. 1999, 22, 159–163. [Google Scholar] [CrossRef]
- Palmieri, L.; Pardo, B.; Lasorsa, F.M.; del Arco, A.; Kobayashi, K.; Iijima, M.; Runswick, M.J.; Walker, J.E.; Saheki, T.; Satrustegui, J.; et al. Citrin and aralar1 are Ca(2+)-stimulated aspartate/glutamate transporters in mitochondria. The EMBO J. 2001, 20, 5060–5069. [Google Scholar] [CrossRef]
- Saheki, T.; Kobayashi, K.; Iijima, M.; Horiuchi, M.; Begum, L.; Jalil, M.A.; Li, M.X.; Lu, Y.B.; Ushikai, M.; Tabata, A.; et al. Adult-onset type II citrullinemia and idiopathic neonatal hepatitis caused by citrin deficiency: Involvement of the aspartate glutamate carrier for urea synthesis and maintenance of the urea cycle. Mol. Genet. Metab. 2004, 81, 20–26. [Google Scholar] [CrossRef]
- Saheki, T.; Song, Y.Z. Citrin Deficiency. In GeneReviews ®; Adam, M.P., Ardinger, H.H., Pagon, R.A., Wallace, S.E., Bean, L.J.H., Stephens, K., Amemiya, A., Eds.; University of Washington: Seattle, Seattle, WA, USA, 2017. [Google Scholar]
- Mutoh, K.; Kurokawa, K.; Kobayashi, K.; Saheki, T. Treatment of a citrin-deficient patient at the early stage of adult-onset type II citrullinaemia with arginine and sodium pyruvate. J. Inherit. Metab. Dis. 2008, 31, 343–347. [Google Scholar] [CrossRef]
- Tenreiro, S.; Outeiro, T.F. Simple is good: Yeast models of neurodegeneration. FEMS Yeast Res. 2010, 10, 970–979. [Google Scholar] [CrossRef]
- Wongkittichote, P.; Tungpradabkul, S.; Wattanasirichaigoon, D.; Jensen, L.T. Prediction of the functional effect of novel SLC25A13 variants using a S. cerevisiae model of AGC2 deficiency. J. Inherit. Metab. Dis. 2013, 36, 821–830. [Google Scholar] [CrossRef]
- Forsburg, S.L. The art and design of genetic screens: Yeast. Nat. Rev. Genet. 2001, 2, 659–668. [Google Scholar] [CrossRef]
- Cavero, S.; Vozza, A.; del Arco, A.; Palmieri, L.; Villa, A.; Blanco, E.; Runswick, M.J.; Walker, J.E.; Cerdan, S.; Palmieri, F.; et al. Identification and metabolic role of the mitochondrial aspartate-glutamate transporter in Saccharomyces cerevisiae. Mol. Microbiol. 2003, 50, 1257–1269. [Google Scholar] [CrossRef] [PubMed]
- Huber, A.; Koch, J.; Kragler, F.; Brocard, C.; Hartig, A. A subtle interplay between three Pex11 proteins shapes de novo formation and fission of peroxisomes. Traffic 2012, 13, 157–167. [Google Scholar] [CrossRef]
- Lee, Y.J.; Jang, J.W.; Kim, K.J.; Maeng, P.J. TCA cycle-independent acetate metabolism via the glyoxylate cycle in Saccharomyces cerevisiae. Yeast 2011, 28, 153–166. [Google Scholar] [CrossRef] [PubMed]
- Pascual-Ahuir, A.; Manzanares-Estreder, S.; Proft, M. Pro- and Antioxidant Functions of the Peroxisome-Mitochondria Connection and Its Impact on Aging and Disease. Oxidative Med. Cell. Longev. 2017, 2017, 9860841. [Google Scholar] [CrossRef]
- Smith, J.J.; Aitchison, J.D. Peroxisomes take shape. Nat. Rev. Mol. Cell Boil. 2013, 14, 803–817. [Google Scholar] [CrossRef]
- Lefevre, S.D.; van Roermund, C.W.; Wanders, R.J.; Veenhuis, M.; van der Klei, I.J. The significance of peroxisome function in chronological aging of Saccharomyces cerevisiae. Aging Cell 2013, 12, 784–793. [Google Scholar] [CrossRef]
- van Roermund, C.W.; Waterham, H.R.; Ijlst, L.; Wanders, R.J. Fatty acid metabolism in Saccharomyces cerevisiae. Cell. Mol. Life Sci. CMLS 2003, 60, 1838–1851. [Google Scholar] [CrossRef]
- Longo, V.D.; Shadel, G.S.; Kaeberlein, M.; Kennedy, B. Replicative and chronological aging in Saccharomyces cerevisiae. Cell Metab. 2012, 16, 18–31. [Google Scholar] [CrossRef]
- Sikorski, R.S.; Hieter, P. A system of shuttle vectors and yeast host strains designed for efficient manipulation of DNA in Saccharomyces cerevisiae. Genetics 1989, 122, 19–27. [Google Scholar]
- Sullivan, J.A.; Lewis, M.J.; Nikko, E.; Pelham, H.R. Multiple interactions drive adaptor-mediated recruitment of the ubiquitin ligase rsp5 to membrane proteins in vivo and in vitro. Mol. Biol. Cell 2007, 18, 2429–2440. [Google Scholar] [CrossRef]
- Bilan, D.S.; Matlashov, M.E.; Gorokhovatsky, A.Y.; Schultz, C.; Enikolopov, G.; Belousov, V.V. Genetically encoded fluorescent indicator for imaging NAD(+)/NADH ratio changes in different cellular compartments. Biochim. Biophys. Acta 2014, 1840, 951–957. [Google Scholar] [CrossRef]
- Brachmann, C.B.; Davies, A.; Cost, G.J.; Caputo, E.; Li, J.; Hieter, P.; Boeke, J.D. Designer deletion strains derived from Saccharomyces cerevisiae S288C: A useful set of strains and plasmids for PCR-mediated gene disruption and other applications. Yeast 1998, 14, 115–132. [Google Scholar] [CrossRef]
- Longtine, M.S.; McKenzie, A., 3rd; Demarini, D.J.; Shah, N.G.; Wach, A.; Brachat, A.; Philippsen, P.; Pringle, J.R. Additional modules for versatile and economical PCR-based gene deletion and modification in Saccharomyces cerevisiae. Yeast 1998, 14, 953–961. [Google Scholar] [CrossRef]
- Gietz, R.D.; Schiestl, R.H. Applications of high efficiency lithium acetate transformation of intact yeast cells using single-stranded nucleic acids as carrier. Yeast 1991, 7, 253–263. [Google Scholar] [CrossRef]
- Sherman, F.; Fink, G.R.; Lawrence, C.W. Methods in Yeast Genetics; Cold Spring Harbor Laboratory Press: Cold Spring Harbor, NY, USA, 1978; pp. 178–179. [Google Scholar]
- Zipor, G.; Haim-Vilmovsky, L.; Gelin-Licht, R.; Gadir, N.; Brocard, C.; Gerst, J.E. Localization of mRNAs coding for peroxisomal proteins in the yeast, Saccharomyces cerevisiae. Proc. National Acad. Sci. USA 2009, 106, 19848–19853. [Google Scholar] [CrossRef]
- Al-Saryi, N.A.; Al-Hejjaj, M.Y.; van Roermund, C.W.T.; Hulmes, G.E.; Ekal, L.; Payton, C.; Wanders, R.J.A.; Hettema, E.H. Two NAD-linked redox shuttles maintain the peroxisomal redox balance in Saccharomyces cerevisiae. Sci. Rep. 2017, 7, 11868. [Google Scholar] [CrossRef]
- Luttik, M.A.; Overkamp, K.M.; Kotter, P.; de Vries, S.; van Dijken, J.P.; Pronk, J.T. The Saccharomyces cerevisiae NDE1 and NDE2 genes encode separate mitochondrial NADH dehydrogenases catalyzing the oxidation of cytosolic NADH. J. Biol. Chem. 1998, 273, 24529–24534. [Google Scholar] [CrossRef]
- Tower, R.J.; Fagarasanu, A.; Aitchison, J.D.; Rachubinski, R.A. The peroxin Pex34p functions with the Pex11 family of peroxisomal divisional proteins to regulate the peroxisome population in yeast. Mol. Boil. Cell 2011, 22, 1727–1738. [Google Scholar] [CrossRef]
- Lewin, A.S.; Hines, V.; Small, G.M. Citrate synthase encoded by the CIT2 gene of Saccharomyces cerevisiae is peroxisomal. Mol. Cell. Boil. 1990, 10, 1399–1405. [Google Scholar] [CrossRef]
- Palmieri, L.; Agrimi, G.; Runswick, M.J.; Fearnley, I.M.; Palmieri, F.; Walker, J.E. Identification in Saccharomyces cerevisiae of two isoforms of a novel mitochondrial transporter for 2-oxoadipate and 2-oxoglutarate. J. Biol. Chem. 2001, 276, 1916–1922. [Google Scholar] [CrossRef]
- Chen, Y.; Siewers, V.; Nielsen, J. Profiling of cytosolic and peroxisomal acetyl-CoA metabolism in Saccharomyces cerevisiae. PLoS ONE 2012, 7, e42475. [Google Scholar] [CrossRef]
- Saheki, T.; Iijima, M.; Li, M.X.; Kobayashi, K.; Horiuchi, M.; Ushikai, M.; Okumura, F.; Meng, X.J.; Inoue, I.; Tajima, A.; et al. Citrin/mitochondrial glycerol-3-phosphate dehydrogenase double knock-out mice recapitulate features of human citrin deficiency. J. Biol. Chem. 2007, 282, 25041–25052. [Google Scholar] [CrossRef]
- Kaeberlein, M.; Andalis, A.A.; Fink, G.R.; Guarente, L. High osmolarity extends life span in Saccharomyces cerevisiae by a mechanism related to calorie restriction. Mol. Cell. Boil. 2002, 22, 8056–8066. [Google Scholar] [CrossRef]
- Torres-Quiroz, F.; Garcia-Marques, S.; Coria, R.; Randez-Gil, F.; Prieto, J.A. The activity of yeast Hog1 MAPK is required during endoplasmic reticulum stress induced by tunicamycin exposure. J. Biol. Chem. 2010, 285, 20088–20096. [Google Scholar] [CrossRef]
- Chalermwat, C.; Thosapornvichai, T.; Wongkittichote, P.; Phillips, J.D.; Cox, J.E.; Jensen, A.N.; Wattanasirichaigoon, D.; Jensen, L.T. Over-expression of the peroxin Pex34p suppresses impaired acetate utilization in yeast lacking the mitochondrial aspartate/glutamate carrier Agc1p. FEMS Yeast Res. 2019, 19, foz078. [Google Scholar] [CrossRef]
- Breitenbach, M.; Rinnerthaler, M.; Hartl, J.; Stincone, A.; Vowinckel, J.; Breitenbach-Koller, H.; Ralser, M. Mitochondria in ageing: There is metabolism beyond the ROS. FEMS Yeast Res. 2014, 14, 198–212. [Google Scholar] [CrossRef]
- Liu, Z.; Butow, R.A. Mitochondrial retrograde signaling. Annu. Rev. Genet. 2006, 40, 159–185. [Google Scholar] [CrossRef]
- Ferdinandusse, S.; Denis, S.; Faust, P.L.; Wanders, R.J. Bile acids: The role of peroxisomes. J. Lipid Res. 2009, 50, 2139–2147. [Google Scholar] [CrossRef]
- Yang, C.H.; Chen, C.Y.; Chou, Y.Y.; Chiu, H.C.; Tsai, W.L.; Shiesh, S.C. Bile acid profiles in neonatal intrahepatic cholestasis caused by citrin deficiency. Clin. Chim. Acta 2017, 475, 28–35. [Google Scholar] [CrossRef]
- Gronemeyer, T.; Wiese, S.; Ofman, R.; Bunse, C.; Pawlas, M.; Hayen, H.; Eisenacher, M.; Stephan, C.; Meyer, H.E.; Waterham, H.R.; et al. The proteome of human liver peroxisomes: Identification of five new peroxisomal constituents by a label-free quantitative proteomics survey. PLoS ONE 2013, 8, e57395. [Google Scholar] [CrossRef]
- Rakhshandehroo, M.; Hooiveld, G.; Muller, M.; Kersten, S. Comparative analysis of gene regulation by the transcription factor PPARalpha between mouse and human. PLoS ONE 2009, 4, e6796. [Google Scholar] [CrossRef] [PubMed]
© 2020 by the authors. Licensee MDPI, Basel, Switzerland. This article is an open access article distributed under the terms and conditions of the Creative Commons Attribution (CC BY) license (http://creativecommons.org/licenses/by/4.0/).







